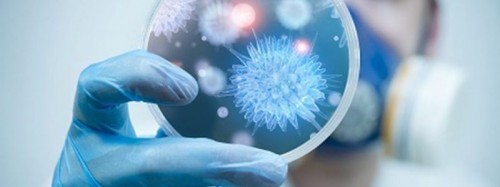
()

В Запорожье начали тотально дезинфицировать подъезды (ВИДЕО)20.03.2020 Сотрудники управляющих компаний города приступили к тщательной дезинфекции подъездов в многоэтажных домах. Так, в связи с тотальным карантином, который призван сдержать распространение смертельно опасного коронавируса по территории Украины, было принято решение обрабатывать подъезды жилых домов дезинфицирующими средствами. Подобной тотальной уборки запорожские многоэтажки “не видели много лет”. Как проходит дезинфекция – смотрите в сюжете телеканала “Алекс”: Джерело: VМесте |
Свежие новости
Пресс-релизы
|
Коментарії:
немає коментарів